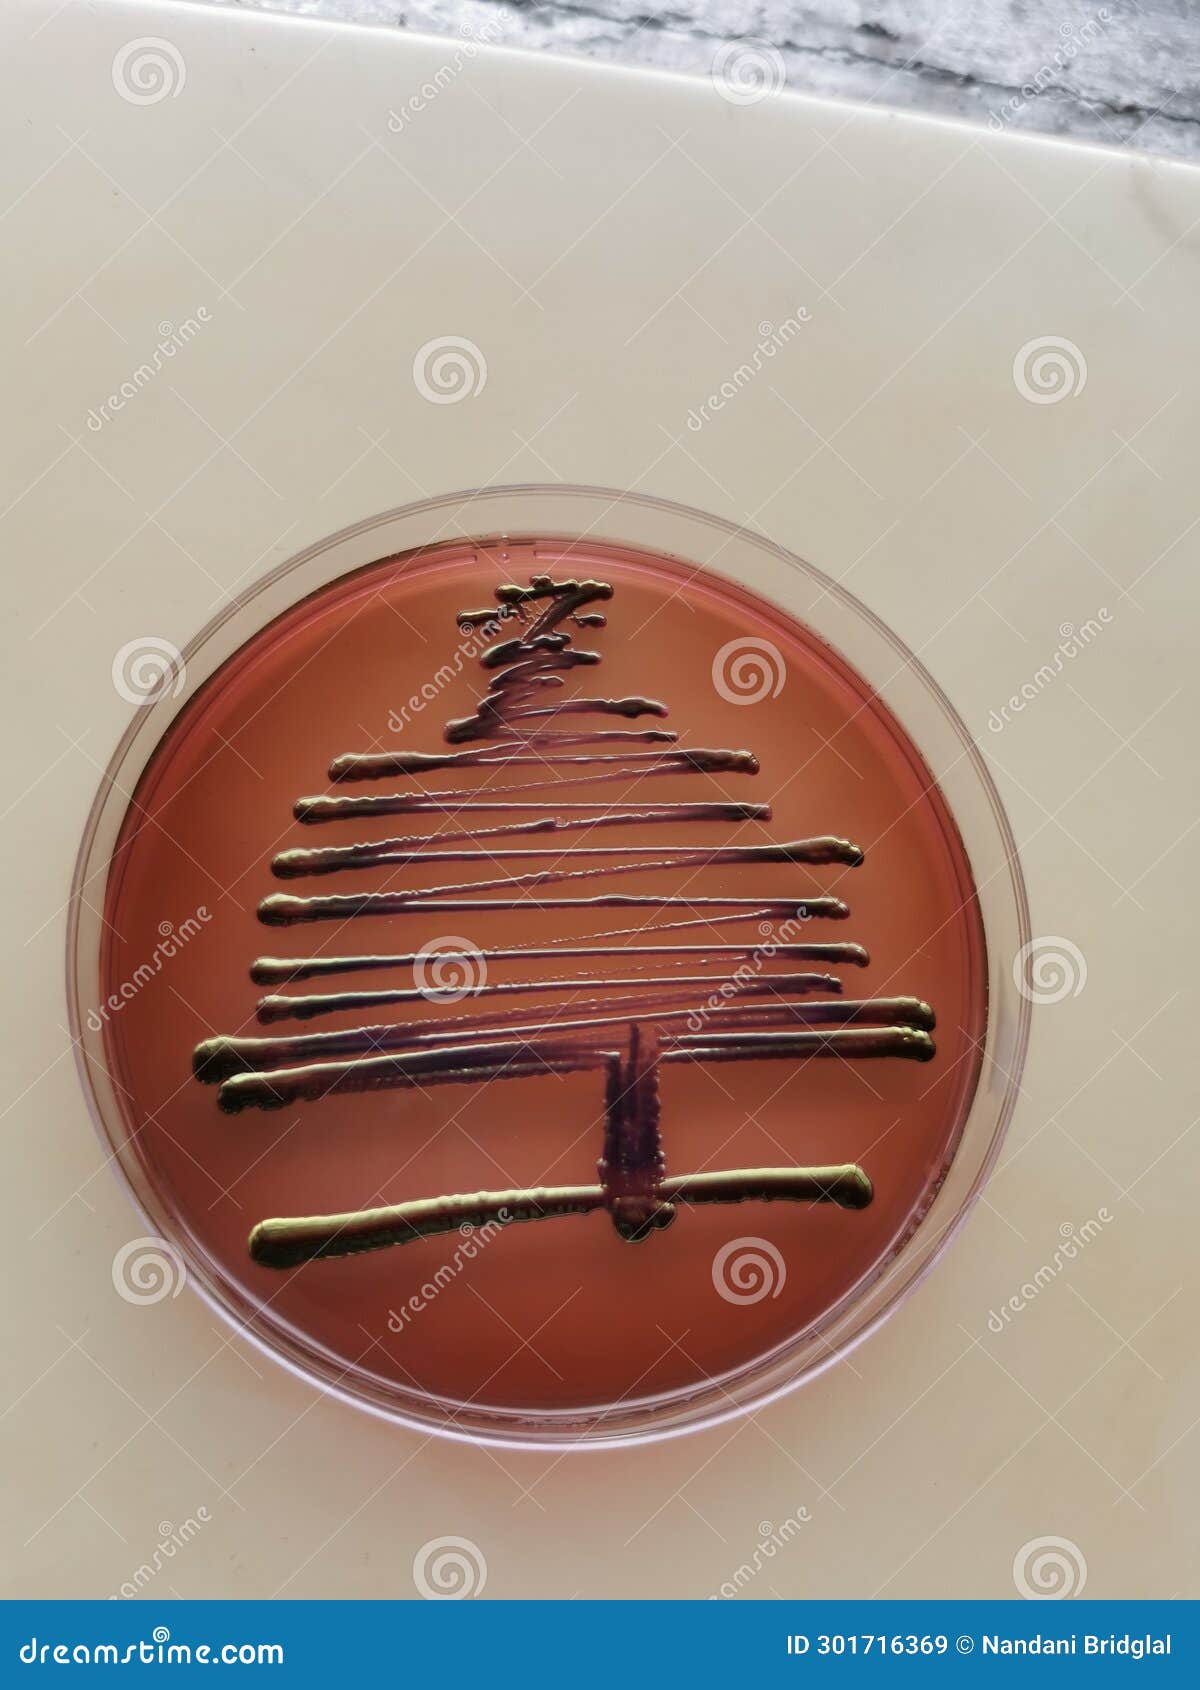
Christmas Tree Pattern of Escherichia Coli Stock Image - Image of escherichia, decorations ...

E Coli Christmas
A girl has been left fighting for her life after she caught a deadly strain of E.coli from food bought at a Christmas market. Antonia Hay, 17, from Buckinghamshire, has spent the past two weeks in. Teenager Antonia Hay's life took a harrowing turn after contracting E.coli during a visit to a Christmas market in Great Missenden, Bucks.

Teenager Contracts E.coli Infection At Christmas Market, Ends Up Fighting For Life At UK Hospital She has been in intensive care for the last two weeks. 3 Antonia in intensive care after 'contracting E. coli at a Christmas market' Credit: GoFundMe 3 The 17-year-old was allowed home for Christmas Day but is back in hospital receiving treatment for kidney failure, her sister said Credit: GoFundMe The bacterial infection causes severe stomach pain, bloody diarrhoea and a fever.

Christmas Tree Pattern of Escherichia Coli Stock Image - Image of biotech, decorations: 301716375
A teenage girl has been fighting for life in hospital after she contracted a strain of E. coli from food bought at a Christmas market. Antonia, 17, has spent the past two weeks in the intensive.

Christmas Girl, 17, fights for life after 'contracting E. coli from Christmas market' Antonia, 17, has been in intensive care for the last two weeks with suspected STEC-HUS, caused by E. coli O157.

60+ Emb Agar Stock Photos, Pictures & Royalty-Free Images - iStock
A teenage girl is fighting for her life after contracting E. coli from food she bought at a Christmas market. Antonia has spent the festive period in intensive care after being admitted to the.

E. coli 'caught at Christmas market' leaves teenage girl fighting for life Antonia Hay, 17, has been in intensive care with the deadly bacterial infection for two weeks and has had multiple. Jemima Hay has launched a fundraising page for sister Antonia, 17, who fell ill after visiting a Christmas market last month.